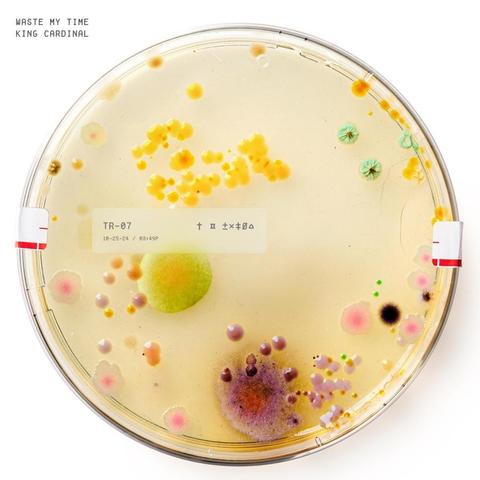

3:35am Say It Like You Mean It by Sleater-Kinney
#KJAC #TheColoradoSound #SleaterKinney
3:32am The Power by Curtis Harding from Departures & Arrivals: Adventures of Captain Curt
#KJAC #TheColoradoSound #CurtisHarding
#KJAC #TheColoradoSound #CurtisHarding
3:06am waste my time by King Cardinal from waste my time - Single
#KJAC #TheColoradoSound #KingCardinal
#KJAC #TheColoradoSound #KingCardinal